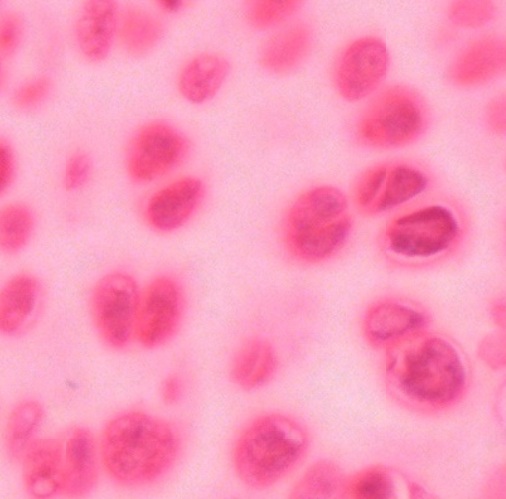
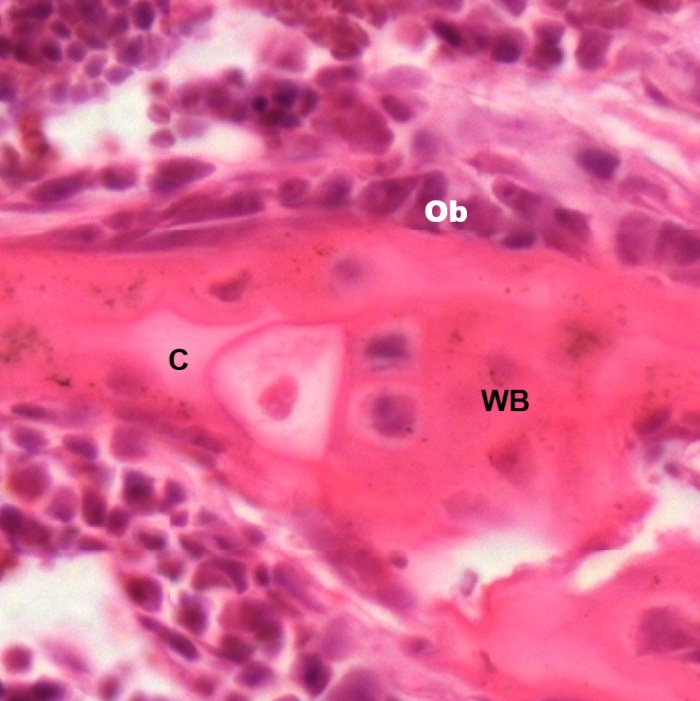

Cartilage and bone are also derived from multipotential mesenchyme. There are three types of cartilage in human body: 1) hyaline cartilage; 2) elastic cartilage; 3) fibrous cartilage. Bone is a vascular connective tissue consisting of cells and calcified intercellular materials. It may be a dense compact bone or a sponge-like cancellous bone.
Hyaline Cartilage
Hyaline cartilage is the most widespread one among three types. It makes up embryonic skeletons and persists in human adult at the ends of bones in free-moving joints as articular cartilage, at the ends of the ribs, and in the nose, larynx, trachea, and bronchi. Here is a cross section of hyaline cartilage (HC) isolated from human trachea (Fig. 4-1). Convex surface faces toward the connective tissue, known as adventitia (A), surrounding the trachea. Concave surface facing tracheal lumen (TL) is continuous with the submucosa (S) underneath the respiratory epithelium which has been removed in preparation. The convex side (Fig. 4-2) shows outer connective tissue, perichondrium (P), and hyaline cartilage (HC) itself from the top to the bottom. The concave side (Fig. 4-3) shows dark stained hyaline cartilage, perichondrium (P), and submucosa (S). Inside the cartilage, chondrocytes (C) are found to be arranged in isogenous groups (Fig. 4-4). They are housed in spaces known as lacunae (L).
Elastic Cartilage
Elastic cartilage is a type of cartilage present in the auricle of the ear giving it shape, providing shape for the lateral region of the external auditory meatus, medial part of the auditory canal, Eustachian tube, corniculate and cuneiform laryngeal cartilages, and epiglottis. In a section of auricle (Fig.4-5) stained by hematoxylin-eosin, elastic cartilage (EC) is found to be embedded in the connective tissue underneath the submucosa of the skin, known as hypodermis (H). In a continuation with the hypodermis, red-stained perichondrium (P) envelops the purple-stained elastic cartilage (Fig. 4-6). Inside the elastic cartilage (Fig. 4-7), chondrocytes (C) are housed in lacunae (L). Occasional lacunae display two chondrocytes (arrow).
Instead of using hematoxylin-eosin stain which cannot reveal elastic fibers in the matrix clearly, Verhoeff’s Elastic stain is used (Fig.4-8). Dark colored elastic fibers are seen in the connective tissue (CT) beneath the epithelium and within the elastic cartilage (EC). Inside the cartilage (Fig. 4-9) elastic fibers (EF) are found to be condensed in the matrix between pale-colored lacunae (L) where chondrocytes (C) are located.
Fibrous Cartilage
It can be found in many locations of the human body, including pubic symphysis, intervertebral discs, glenoid labrum of shoulder joint, acetabular labrum of hip joint, etc. It consists of a mixture of white fibrous tissue and cartilaginous tissue in various proportions (Fig. 4-10). The chondrocytes (C) with deep-stained nuclei are aligned in parallel rows, housed singly in individual lacunae. Bundles of collagen fibers (CF) are found to be arranged in a more or less regular fashion between the rows of chondrocytes (Figs. 4-11 and 4-12).
Compact Bone
The compact bone is also known as cortical bone forming the hard exterior (cortex) of bones. In a thin ground section (Fig. 4-13), the structure of a compact bone can also be observed clearly. It is composed of outer circumferential lamellae (OCL) and inner circumferential lamellae (ICL). Both consist of multiple densely packed microscopic columns, i.e., osteons or Haversian systems. Cross sections of the columns (Figs. 4-14 and 4-15) reveal that each Haversian system (HS) is formed by concentric lamellae (CL). These lamellae contain multiple layers of osteoblasts and osteocytes around a central canal called the Haversian canal (HC). Osteoblasts and osteocytes did not survive after preparation, but many lacunae (La) housing them can be seen. Numerous canaliculi (C) are seen spreading out from lacunae. Volkmann’s canals (VC) at right angles connect the osteons together (Fig. 4-16).
In a longitudinal section of ground compact bone cutting parallel to the bony column (Fig. 4-17), the organization of concentric lamellae cannot be seen. It is found that Haversian canals (HC) are found to be in long shapes. A Volkmann’s canals (VC) can be seen to connect with Haversian canal (HC) at right angles. The histological structure of a compact bone can be enhanced by treating the ground section with silver impregnation (Fig. 4-19). It is shown clearly that each Haversian system is made up of concentric circles surrounding the centrally located canal Haversian canal (HC). Each concentric line is organized by lacunae (La) where the osteocytes are housed. Numerous canaliculi (C) are seen spreading out from lacunae. Lamellae are found between concentric lines. A Volkman’s canal (VC) interconnected between two Haversian canals can be seen (Fig. 4-20). All stained objects in lacunae, Haversian canals, or Volkman’s canal are not cellular but just stained precipitates.
In a paraffin section of compact bone after decalcification and staining with hematoxylin and eosin (Fig. Fig. 4-21), the organization of concentric lamellae is not as clear as being observed in ground section but the formation of Haversian system using Haversian canal (HC) as a center still can be recognized. Osteocytes or Osteoblasts (O) can be observed to be located in lacunae (Fig. 4-22). They have densely stained, irregular nuclei and pale, basophilic cytoplasm. Their cytoplasmic processes (C) can be barely seen inside the canaliculi. On the outer surface of compact bone (Fig. 4-23), there is a layer of condensed fibrous tissue covering the bone, known as periosteum (P), containing numerous osteoprogenitor cells (OC) which look like fibroblasts. Between periosteum and mature lamellar bone (LB), there is a layer of immature bone, known as woven bone (WB), which is pale stained and contains no bone lamellae. The separation of periosteum from woven bone is caused during tissue preparation.
Spongy Bone
It is also known as cancellous bone (Fig. 4-24) and is composed of a network of bony trabeculae (T) separated by a labyrinth of interconnecting spaces containing bone marrow (BM). The trabeculae (Fig. 4-25) are composed of irregular lamellae of bone with lacunae containing osteocytes (O). They are lined by a layer of endosteum (arrows) which is a thin vascular connective tissue membrane on the surface of woven bone (WB), containing osteocytes with cytoplasmic processes surrounded by collagenous fibers-filled matrix (Fig. 4-26). The lamellar bone (LB) is next to the woven bone. Osteoprogenitor cells, osteoblasts (B), and osteoclasts (C) can be found in the endosteum. Spongy bone may not contain Haversian systems. Osteocytes may exchange metabolites through canaliculi with blood sinusoid in the marrow.
Bone Development
During fetal development bone occurs in two ways involving replacement of primitive collagenous tissue by bone. Then the immature bone, or woven bone, is extensively remodeled by reabsorption and appositional growth to form adult lamellar bone. Long bones, vertebrae, pelvis and bones of skull base are known as cartilage bones because they are formed through a progressive replacement from continuously growing cartilage. This process is called endochondral ossification. The bones of skull vault, maxilla and most mandible bones are formed by deposition of bone within primitive mesenchymal tissue. It is a process of direct replacement of mesenchyme by bone, known as intramembranous ossification. The bones so formed are called membrane bones.
Endochondral Ossification
A longitudinal section of fetal finger stained by hematoxylin and eosin (Fig. 4-27) is a good example to illustrate both primary ossifications occurring in diaphysis (D), or called shaft of a long bone, and secondary ossification occurring in epiphysis (E). The cartilaginous epiphysis is separated from the diaphysis by the epiphyseal growth plate (P), which provides for growth in length of long bone. A secondary ossification center (SC) in epiphyses where bone formation begins after birth, contributes to the growth and development of the skeleton. These centers eventually fuse with the primary ossification center in the bone shaft to form the mature adult bone.
Detailed process of endochondral ossification can be revealed by a transition (Fig. 4-28) between epiphyseal cartilage (E) and new bone (B) in the following six sequential zones (Fig. 4-29):
1) Zone of reserve cartilage (R) consists of typical hyaline cartilage with chondrocytes arranged in small clusters surrounded by large amount of matrix (Fig. 4-30).
2) Zone of proliferation (P) shows successive mitotic divisions of clustering cartilages cells to form columns of chondrocytes (Fig. 4-31).
3) Zone of maturation (M) reveals the stop of cell division size increase of chondrocytes (Fig. 4-32).
4) Zone of hypertrophy and calcification (H) is characterized by greatly enlarged and vacuolated chondrocytes within calcified matrix (Fig. 4-33).
5) Zone of cartilage degeneration (D) shows degenerated chondrocytes and invasion of osteogenic cells and capillaries from the marrow cavity of the diaphysis (Fig. 4-34).
6) Osteogenic zone (O), also known as metaphysis, shows that osteoblasts differentiated from osteogenic cells congregate on the surface of the newly formed woven bone (Fig. 4-35).
In metaphysis (Fig. 4-36), the newly formed woven bone (WB) embraces a core of light stained spicules of calcified cartilage matrix (C). Numerous osteoblasts (Ob) can be seen on the surface. Except the osteoblasts (Ob), some osteoclasts (Oc) are also found (Fig. 4-37). They play an important role in bone reabsorption during bone maturation and bone remodeling. Osteocytes (C) in lacunae can be also seen in the woven bone (WB).
Intramembranous Ossification
A section of fetal skull is used to illustrate the process of intramembranous bone formation (Fig. 4-38). Between outer periosteum (Po) and inner periosteum (Pi), there are developing osteal trabeculae (T) of the skull (Fig. 4-39). At the junction between periosteum and developing trabeculae (Fig. 4-40), many progenitor cells of osteoblasts (arrows) can be seen as star-shaped or spindle cells within the periosteum (P). Many osteoblasts (Ob) and osteoclasts (Oc) can be seen to be attached to the surface of osteal trabeculae (T). Inside the trabeculae, osteoblasts (Ob) and osteocytes (O) are seen to be housed in lacunae (L). At some locations (Fig. 4-41), osteoclast (Oc) is found to reabsorb osteoid and form a shallow depression on the bone surface, known as Howship’s lacunae (arrows).
NOTE:
- Only those organelles visible under the light microscope are discussed here. It is suggested that to study all organelles visible under the electron microscope through your histology textbook and atlas.
- All photos used for discussion are taken from DSMH digital slides as follows:
H030060 Hyaline Cartilage, sec. of trachea, human, HE. (Figs. 4-1, 4-2, 4-3, 4-4)
H030070 Elastic Cartilage, sec. of auricle, human, HE. (Figs. 4-5, 4-6, 4-7)
H030080 Elastic Cartilage, sec. of auricle showing elastic fibers, human, VE. (Figs. 4-8, 4-9)
H030090 Fibrous Cartilage, sec., human, HE. (Figs. 4-1-, 4-11, 4-12)
H030100 Compact Bone, ground sec., human SI., human. (Figs. 4-19, 4-20)
H030102 Compact Bone, ground preparation, cs., human. (Figs. 4-13, 4-14, 4-15, 4-16)
H030103 Compact Bone, ground preparation, ls., human. (Figs. 4-17, 4-18)
H030111 Decalcified Bone, cs., human, HE. (Figs. 4-21, 4-22, 4-23)
H030112 Decalcified Bone, ls., human, HE. (Figs. 4-24, 4-25, 4-26)
H030120 Developing Cartilage Bone, showing endochondral bone formation of infant, sec., human, HE. (Figs. 4-27, 4-28, 4-29, 4-30, 4-31, 4-32, 4-33, 4-34, 4-35, 4-26, 4-37)
H030130 Developing Membrane Bone, showing intramembranous bone formation of infant, sec., human, HE. (Figs. 4-38, 4-39, 4-40, 4-41) - Staining methods and results:
HE = hematoxylin and eosin, is used to stain cell nuclei blue and cytoplasm pink or red. Hematoxylin may also stain ribosomes and rough endoplasmic reticulum blue.
SI = silver impregnation, is used to demonstrate neurons and processes in black or brown.
VE = Verhoeff’s elastic stain, is used to stain elastic fibers and nuclei black, collagen red and cytoplasmic elements yellow.